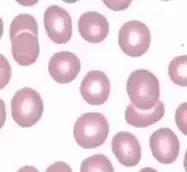
外周血细胞涂片的正常值,外周血细胞分析多长时间出结果
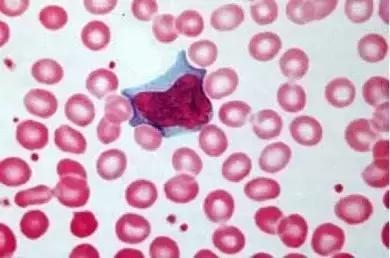
外周血细胞涂片的正常值,外周血细胞分析多长时间出结果
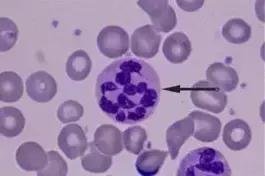
外周血细胞涂片的正常值,外周血细胞分析多长时间出结果
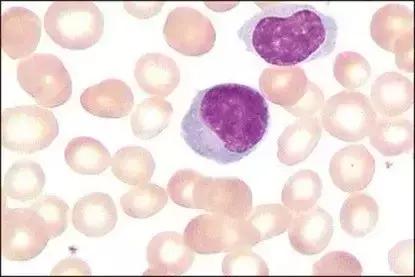
外周血细胞涂片的正常值,外周血细胞分析多长时间出结果
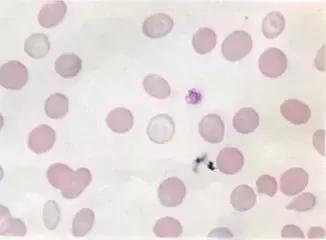
外周血细胞涂片的正常值,外周血细胞分析多长时间出结果
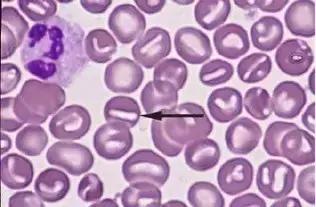
外周血细胞涂片的正常值,外周血细胞分析多长时间出结果
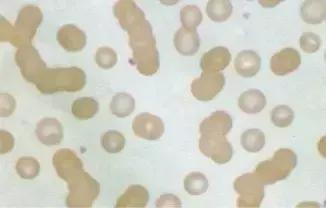
外周血细胞涂片的正常值,外周血细胞分析多长时间出结果

听说小伙伴们最近在看外周血涂片?
显微镜下一片片的细胞究竟都是些什么?

以前学习过的正常的细胞形态都已经忘记了?!
不要慌,十分钟了解外周血图片!
外周血涂片镜检的基本知识
血液,是人体的一面镜子,动态反映了机体造血、营养、免疫等多方面的状态。要了解患者的血细胞,外周血涂片镜检无疑是最经济、最快速的手段。但在今天,即使是血液科,亲自动手镜检的临床医生也已少之又少。鉴于血细胞形态学的专业性,方便临床医生判读检验结果,促进沟通,在此向读者简要介绍外周血涂片镜检的基本知识。
适用范围
对于有发热待查、贫血、出血、肝脾及外周淋巴结肿大等患者,及其他需要在血常规机检项目外检查血细胞数量与形态的患者均适用。
样本采集与制片
成年患者常于肘静脉处采血,儿童患者也可以使用采集自指尖或足跟的末梢血样本。血液应以EDTA-K2抗凝(紫色抗凝管)。此外,使用肝素锂&肝素钠抗凝的绿管不适用,因其常导致镜下白细胞聚集,且易出现蓝色的背景,干扰观察;含枸橼酸钠的黑管(血沉管)和蓝管(血凝管)也不常规使用。制片常采用薄血膜法,易于制备、细胞形态舒展容易观察,但检查疟原虫、锥虫、微丝蚴等血液寄生虫时厚血膜制片更佳。
染色
一般使用瑞氏(Wright)染色,其中偏碱性的亚甲蓝能结合于核酸分子和酸性蛋白质,使这些结构呈蓝色;偏酸性的伊红能结合于碱性蛋白质,使之呈红色;中性蛋白质呈浅紫红色。瑞氏染色对细胞结构染色较好,但有时对染色质着色不深,此类标本可加用吉姆萨(Giemsa)染料,称瑞氏-吉姆萨染色。吉姆萨染色对细胞核染色效果好,故常用于细胞染色体检查、厚薄血膜镜检查疟原虫等。

镜下常见血细胞形态
红细胞
在染色良好的涂片中,血红蛋白结合伊红,红细胞呈粉红至红色,中央因双凹圆盘结构而呈现空白,平均直径7μm。红细胞也常作为镜下评价血涂片染色质量和患者血红蛋白含量的参照物,如红细胞染色整体偏蓝,则常提示染液过碱,染液过酸时则红细胞颜色明显偏红;如红细胞颜色过淡、体积大小不均一,中央淡染区扩大,常提示缺铁性贫血。
下图中的红色圆形至椭圆形细胞均为染色良好的成熟红细胞:
染液过酸导致视野整体偏红(视野中央为异型淋巴细胞):
染液过碱导致视野整体偏蓝(视野中、左分别为杆状核中性粒细胞和分叶核中性粒细胞):

中性粒细胞
中性粒细胞胞体圆形至椭圆形,直径10-15μm。细胞质中密布细小的嗜中性颗粒,故染色后呈均一的浅紫红色;细胞核形态多样,可呈长杆状,也可为分叶状核,分2-5叶不等。核染色质呈粗条索至块状,结构紧密。
观察白细胞时应特别注意观察的顺序。
先依据镜下红细胞的大小粗估细胞直径,再看细胞核是否圆整饱满、占整个细胞面积百分比如何(细胞核越圆整、占比越大,则细胞越幼稚)。以此大致估计细胞分化阶段后,应认真观察细胞核的形状和核染色质聚集程度,幼稚细胞的染色质聚集程度低因而常呈细沙状、细颗粒状,成熟细胞则往往呈紧密的粗条索状或团块状(作为例外,成熟单核细胞的染色质常为细网状或细条索状)。确定细胞的分化阶段后,仔细观察胞浆的颜色、粗糙程度、所含颗粒、是否有包涵体等特殊结构,以确定细胞的分类。
杆状核中性粒细胞(本例中性粒细胞胞质出现粗大紫红色的嗜天青颗粒):

2分叶的分叶核中性粒细胞:

巨多分叶中性粒细胞(箭头所指,常见于叶酸和vB12缺乏所致巨幼贫):
单核细胞
单核细胞胞体圆至椭圆形,直径12-20μm,胞浆灰蓝色且稍有粗糙感,半透明似毛玻璃,胞质中常有小空泡。成熟的单核细胞胞核呈肾形、马蹄形、不规则形等,细胞核常有扭曲和折叠感,胞核的切迹(深凹)也较中性粒细胞更明显。核染色质呈细条索状,细致疏松,以此区别于中性粒细胞。
下图为典型的成熟单核细胞,胞浆灰蓝色半透明,有粗糙感,胞核染色质细网状,较疏松,胞核形状不规则:

下图左侧(箭头所指)为单核细胞,右侧为杆状核中性粒细胞。对比可见单核细胞胞浆偏灰蓝且更粗糙,中性粒细胞浆因含大量嗜中性颗粒而呈现均一的浅紫红色。单核细胞胞核有明显的扭曲感,而中性粒细胞的核染色质则更加紧密(染色较深、深紫红色的染色质团块较大)、粗糙:

淋巴细胞
分大淋巴细胞(直径12-15μm)、小淋巴细胞(直径6-9μm)两大类,细胞圆形或椭圆形,胞质淡蓝色透明,无颗粒或偶有数颗紫红色的嗜天青颗粒。胞核圆形,直径接近细胞直径80%,染色质呈浓集的团块状,染色质中偶有1个或多个染色较浅的小区域,称为假核仁或副染色质。
下图所示为2个大淋巴细胞:
嗜酸性粒细胞
嗜酸性粒细胞直径13-15μm,胞浆中充满大小均一如粟粒的橙色颗粒,这是细胞中富含阳离子蛋白的嗜酸性颗粒结合了伊红染料形成的。在染色较深的涂片中,嗜酸性颗粒往往呈现深橙色、棕色至咖啡色,未成熟的嗜酸性粒细胞也可混杂有少量深紫红色的嗜天青颗粒,但这些颗粒绝不会重叠到细胞核上,以此可以与嗜碱性粒细胞的颗粒相区别。它的细胞核也很有特点,绝大多数是2分叶,细胞核小而饱满,形似眼镜,故有“眼镜核”的说法。偶见3分叶核。
下图为2分叶核的嗜酸性粒细胞(染色稍偏酸):

嗜碱性粒细胞
嗜碱性粒细胞:略小于中性粒细胞(10-12μm),细胞内可见较多的深紫黑色嗜碱性颗粒,较嗜酸性颗粒更为粗大,常覆盖在细胞核上。

血小板
血小板:散落或聚集分布于红细胞周围,直径约1-3μm,灰蓝色略粗糙胞浆,有点状或细网状核酸存在于细胞中。
如下图,散落于红细胞间的紫红色颗粒就是血小板,箭头所示三处血小板有明显的大小分布不均。

异常红细胞
低色素性红细胞:红细胞中央的空白淡染区扩大,颜色减淡。是细胞内血红蛋白含量不足所致,最常见的原因是缺铁性贫血。

红细胞双相性:血涂片中兼有典型的正常红细胞与低色素性红细胞,这种表现常见于铁粒幼红细胞性贫血。
球形红细胞:常见于遗传性球形红细胞增多症患者,自身免疫性溶血性贫血也常见。表现为比正常红细胞更深的染色,体积小而圆。

口形红细胞:形似张开的鱼口,常见于遗传性口形红细胞增多症。
泪滴形红细胞:细胞一端被拉长,形成泪滴般。骨髓纤维化患者可以见到。

棘红细胞:细胞表面多个较细长的突起,长度各异,分布不规则。常提示患者患有肝硬化或红细胞酶代谢异常,但也可能是玻璃水渍导致的碱溶出。

缗钱样红细胞:细胞在镜下互相黏连成串,常是由于多发性骨髓瘤产生大量M蛋白,或巨球蛋白血症、高纤维蛋白血症等原因所致。
参考文献
[1] 2007-2014年卫生部形态学室间质评所用图片
[2] 三轮史朗,渡边阳之辅《血细胞图谱》。
◎◎◎治趣,临床诊疗能力提升必备工具!◎◎◎
关注“治趣”公众号,回复“病例讲义+QQ邮箱”,免费领取知名三甲医院独家病例讲义!
新浪微博:@治趣
治趣线上体验:www.curefun.com
各大应用商店“治趣”已上架,欢迎*载下**体验!